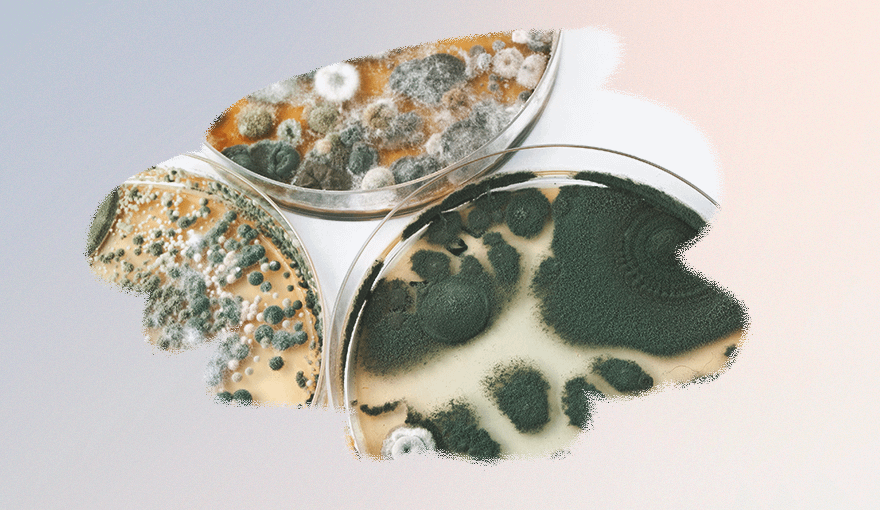

1. Аллергия вызывает боль и неприятные ощущения в языке
Болит язык часто у людей с аллергией. От определенных продуктов на нем могут появиться неприятные ощущения.
Чаще всего их испытывают люди с аллергией на пыльцу. В этом случае неприятная реакция возникает, если белок в продуктах схож с ее белком по составу. К таким продуктам относятся яблоки, персики, вишня, груши и другие плоды растений семейства розоцветные. Наряду с болью, люди испытывают ощущение зуда и першение в горле. Также может появиться отек губ, языка, повышенное слезотечение и насморк.
2. Языкоглоточная невралгия приводит к тому, что болит язык
Если невралгия поражает нерв, который находится у корня языка, она называется языкоглоточной. Это состояние характеризуется сильной, ноющей болью, нередко возникающей в виде приступов, которые длятся в среднем две минуты. Помимо языка неприятные ощущения затрагивают уши, миндалины, горло.
К счастью, такая форма невралгии встречается достаточно редко. Чаще всего она поражает людей старше 40 лет.
3. Иногда болит язык из-за молочницы
Молочница вызывается грибком типа Candida. Он присутствует во рту, горле, пищевом тракте. При нормальном состоянии здоровья он никак себя не проявляет. Но в некоторых случаях, например, иммунной недостаточности, грибки становятся возбудителями инфекции.
Они поражают слизистые оболочки, в том числе рта и горла. Молочница нередко сопровождается появлением на языке белых шишек, а также болезненными ощущениями. Вкус пищи при этом заболевании может измениться: стать странным, а некоторые привычные продукты показаться неприятными.
4. Синдром горящего рта — еще одна причина боли в языке
Это хроническое и трудно поддающееся лечению заболевание. Чаще всего оно встречается у женщин, переживающих менопаузу или климакс.
При синдроме горящего рта есть целый ряд неприятных и изнуряющих симптомов, помимо боли в языке: покалывание, жжение, онемение. Нередко изменяется вкус пищи, а также возникает сухость слизистой рта и горла, что приводит к постоянному чувству жажды.
5. Болезнь Бехчета приводит к тому, что болит язык
Это хроническое воспаление кровеносных сосудов по всему телу. Оно сопровождается появлением корок и язв во рту. Именно они вызывают болезненные ощущения.
Причина заболевания, к сожалению, точно неизвестна. Врачи предполагают, что оно может быть возникнуть на фоне аутоиммунных патологических состояний, а также вирусных и бактериальных поражений.
6. Травма языка может вызвать боль
Наверняка ты хоть раз в жизни случайно прикусывала язык во время еды или тренировки. Это может привести не только к краткосрочной, но и продолжительной боли.
Подобные ощущения вызывают и ожоги, полученные от приема горячей пищи и напитков. Так же, как и при травмах конечностей, не стоит пренебрегать консультацией у врача, особенно если боль не проходит в течение длительного времени.
7. Болит язык из-за глоссита
Воспаление языка называется глосситом. Он возникает по разным причинам, например, бактериальной инфекции или другого патологического состояния организма. Глоссит также может возникнуть, как самостоятельное заболевание.
Из-за глоссита болит язык, во рту возникает чувство жжения и повышенное слюноотделение. Ощущения от приема пищи могут измениться. Если болезнь долго не лечить, могут появиться более серьезные симптомы. Становится трудно глотать, речь может стать неразборчивой, на языке образуются высыпания, похожие на папилломы.
8. Герпес может вызвать язвы на языке
Небольшие раны на слизистой оболочке рта могут быть вызваны герпесом. Это вирусное заболевание, которое легко передается через поцелуи и другие контакты. Как правило, раны и язвы при герпесе возникают на поверхности губ, но в некоторых случаях могут затрагивать и язык. Из-за этого в нем появляются болезненные ощущения.
9. Из-за пищи и других раздражителей
Некоторые люди испытывают боль при приеме определенной пищи, например, очень острой или кислой. Неприятные ощущения могут варьироваться от незначительных до острых и жгучих, которые сложно терпеть. Они могут пройти через полчаса после приема пищи или остаться надолго.
Подобным действием может обладать и зубная паста, жевательная резинка или ополаскиватель полости рта. Если человек чувствителен к их компонентам, он испытает болевые ощущения.
10. Болезни желудочно-кишечного тракта влияют на состояние языка
Состояние языка и ротовой полости значительно зависит от здоровья желудочно-кишечного тракта. И когда оно нарушено, появляются неприятные симптомы. Например, боль у корня языка, которая сопровождается чувством жжения, может быть признаком гастрита. При других патологиях ЖКТ язык может болеть во время изжоги или натощак.
 Читать по теме:8 причин, почему может появиться металлический привкус во рту
Читать по теме:8 причин, почему может появиться металлический привкус во рту